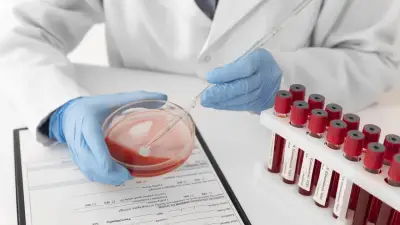
IPS de Medellín atenderá a 250 pacientes con hemofilia de Nueva EPS sin medicación

La ELA: una enfermedad que afecta a más de 3.000 colombianos
La reciente muerte del actor estadounidense Eric Dane, conocido por sus papeles en Grey's Anatomy y Euphoria, ha puesto nuevamente en el foco público a la Esclerosis Lateral Amiotrófica (ELA), una patología neurodegenerativa progresiva que en Colombia afecta aproximadamente a 3.000 personas. Dane falleció a los 53 años, apenas un año después de haber anunciado públicamente su diagnóstico, según confirmó su familia en un comunicado difundido por la revista People.
¿Qué es exactamente la Esclerosis Lateral Amiotrófica?
La ELA, también denominada enfermedad de Lou Gehrig, es una condición del sistema nervioso que ataca específicamente las neuronas motoras del cerebro y la médula espinal. Estas células son responsables del control del movimiento voluntario, por lo que su deterioro progresivo provoca debilidad y atrofia muscular que puede extenderse hasta comprometer funciones vitales como hablar, tragar y respirar.
La enfermedad suele manifestarse inicialmente con debilidad muscular localizada en manos, brazos o piernas, síntomas que frecuentemente pasan desapercibidos en sus primeras etapas. Con el tiempo, la afectación se expande a otros grupos musculares, generando una parálisis progresiva que impacta profundamente la autonomía y calidad de vida de los pacientes.
Aunque la ELA no afecta el intelecto, los sentidos ni órganos como el corazón o los intestinos, en fases avanzadas la falla de los músculos respiratorios se convierte en la principal causa de fallecimiento, a menos que se implemente asistencia mecánica permanente.
La realidad de la ELA en Colombia
En nuestro país, la ELA está clasificada como enfermedad huérfana. Se registran alrededor de cuatro nuevos casos mensuales, con una edad promedio de diagnóstico de 55 años. Más del 50% de los casos se concentran en Bogotá, Antioquia y Valle del Cauca, y aunque afecta tanto a hombres como a mujeres, presenta una mayor incidencia en varones con una proporción de entre 1,5 y 2 por cada mujer diagnosticada.
El proceso diagnóstico resulta particularmente complejo ya que no existe una prueba única que confirme la enfermedad. Generalmente requiere meses o incluso años de evaluaciones, incluyendo exámenes neurológicos completos y diversas pruebas para descartar otras patologías con síntomas similares:
- Estudios electrodiagnósticos
- Exámenes de sangre especializados
- Resonancias magnéticas
- Punciones lumbares en casos específicos
- Biopsias musculares cuando se considera necesario
Tratamientos disponibles y su cobertura en Colombia
Aunque actualmente no existe cura para la ELA, sí se dispone de tratamientos que buscan ralentizar su progresión y mejorar la calidad de vida de los pacientes. Entre los medicamentos aprobados se encuentran:
- Riluzol: primer fármaco aprobado que ha demostrado prolongar la supervivencia en algunos pacientes
- Edaravona: medicamento que muestra beneficios modestos en desacelerar el deterioro funcional
- AMX0035: tratamiento más reciente que también ha mostrado efectos positivos en la sobrevida
En Colombia, el tratamiento integral de la ELA está completamente cubierto por el sistema de salud. Aunque la mayoría de los medicamentos y tecnologías requeridas están clasificados como No POS, se financian a través de los recursos dispuestos en los presupuestos máximos del Sistema General de Seguridad Social en Salud. Esto significa que, mientras el paciente esté afiliado al sistema, el tratamiento no tiene costo directo para él o su familia.
La atención multidisciplinaria constituye otro pilar fundamental en el manejo de esta enfermedad. Equipos conformados por neurólogos, fisioterapeutas, terapeutas respiratorios, nutricionistas y otros profesionales especializados trabajan coordinadamente para controlar síntomas, preservar la mayor independencia posible y mejorar tanto la calidad como la expectativa de vida de los pacientes.
Casos que inspiran esperanza
La experiencia del físico Stephen Hawking, quien convivió con la ELA durante 55 años, demuestra que aunque el pronóstico suele ser reservado, un abordaje integral y especializado puede marcar una diferencia significativa en la evolución de la enfermedad.
Eric Dane, durante su último año de vida, se convirtió en un defensor activo de la concienciación e investigación sobre la ELA, siguiendo el ejemplo de otras figuras públicas que han utilizado su visibilidad para dar a conocer esta condición y promover mayores recursos para su estudio y tratamiento.